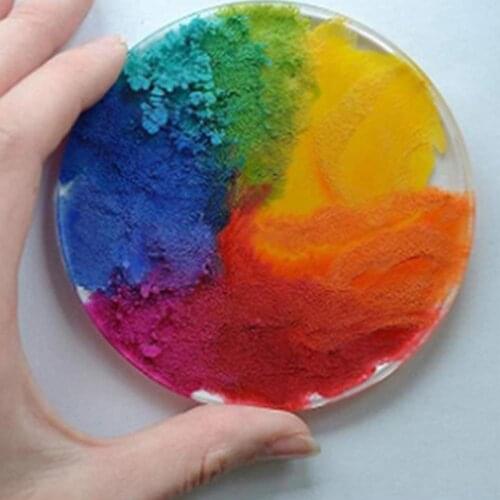
1pcs Dyeing Pearlescent Pigment Additives For DIY Powder Dyeing Pigment For Slime Pigment Slime Accessorie Mud Decoration F B3E2

Cheap plasticine
5418 Plasticine Found. Average value products in Plasticine rubric: $6.
Price: $0.01
Old Price: $0.02Kids Baby Toy Store
Price: $0.01
Kids Baby Toy Store
Price: $0.02
Old Price: $0.04Happiness Childhood Toy Store
Price: $0.02
Old Price: $0.04Kids Baby Toy Store
Price: $0.02
Old Price: $0.03DZ Augenstern Store
Price: $0.03
Old Price: $0.15Kids Baby Toy Store
Price: $0.04
Old Price: $0.06Happiness Childhood Toy Store
Price: $0.04
Old Price: $0.06Unshrek Toy Store
Price: $0.04
Old Price: $0.06Sinsoledad Ego Store
Price: $0.05
Fithit gift Store
Price: $0.05
Unshrek Toy Store
Price: $0.07
Kids Baby Toy Store
Price: $0.08
Old Price: $0.12Lulala~ Store
Price: $0.08
Sinsoledad Ego Store
Price: $0.08
Unshrek Toy Store
Price: $0.1
Old Price: $0.25KingKids Store
Price: $0.1
Lulala~ Store
Price: $0.1
Old Price: $0.25GISIGN Toy Store
Price: $0.1
babytoy88 Store
Price: $0.1
Old Price: $0.14Sinsoledad Ego Store
Price: $0.1
Kids Baby Toy Store
Price: $0.1
Old Price: $0.14babytoy88 Store
Price: $0.11
CrazJoy Store
Price: $0.11
PG Wonderland Store
Price: $0.12
PG Wonderland Store
Price: $0.12
Old Price: $0.17Happiness Childhood Toy Store
Price: $0.12
Old Price: $0.25Gkotta Moment Store
Price: $0.12
Old Price: $0.16Sinsoledad Ego Store
Price: $0.13
Old Price: $0.2Childhood Lullaby Store
Price: $0.13
Shop5573027 Store
Price: $0.13
Warm childhood Store
Price: $0.13
Old Price: $0.22Kids Childhood Store
Price: $0.14
Old Price: $0.21BBtoy2019 Store
Price: $0.14
Old Price: $0.21BBtoy2019 Store
Price: $0.14
Happiness Childhood Toy Store
Price: $0.15
Old Price: $0.22MiMI TOY Store
Price: $0.15
Kenna's Baby Store
Price: $0.15
Happiness Childhood Toy Store
Price: $0.15
babytoy88 Store
Price: $0.15
See you tomorrow 2022 Store
Price: $0.15
Old Price: $0.28Baby Life Toy Store
Price: $0.16
Amusing Toys Store
Price: $0.16
Old Price: $0.28BabyKingdom Toy Store
Price: $0.17
Old Price: $0.28Baby Needed Store
Price: $0.17
Fantasty House Store
Price: $0.17
Old Price: $0.25Wonderland Toy in Store
Price: $0.17
Old Price: $0.25Kiddo Zone Toy Store
Price: $0.17
Old Price: $0.3Angel-Baby Store
Price: $0.17
Old Price: $0.23Sinsoledad Ego Store
Price: $0.17
Price: $0.17
BBtoy2019 Store
Price: $0.17
Old Price: $0.23Sinsoledad Ego Store
Price: $0.17
Toy park Store
Price: $0.18
Lulala~ Store
Price: $0.18
Old Price: $0.26Lulala~ Store
Price: $0.19
Old Price: $0.48TopMask Store
Price: $0.19
Old Price: $0.26Sinsoledad Ego Store
Price: $0.19
Shopfiytoys Store